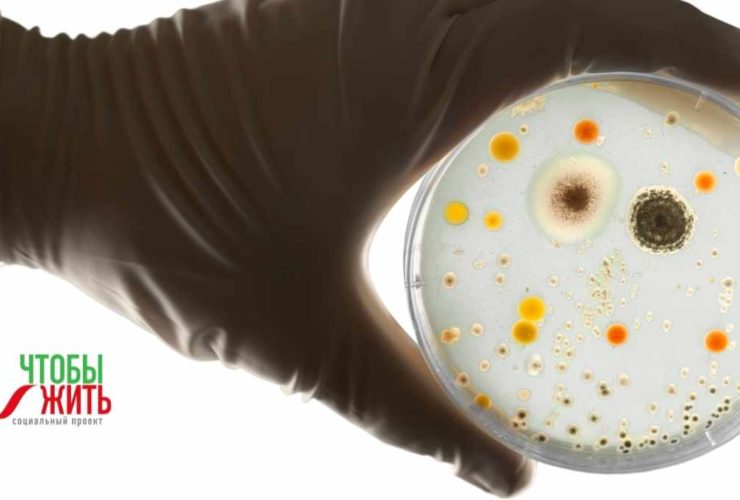

Птичий грипп, свиной грипп и другие вирусные инфекции зоонозного гриппа у людей могут приводить к болезни, протекающей как легкая инфекция верхних дыхательных путей (повышенная температура и кашель) с отделением мокроты на ранней стадии, которая может быстро прогрессировать до развития тяжелой ...
Рак является одной из ведущих причин смерти детей и подростков. Вероятность выживания ребенка с диагностированным раком зависит от того, в какой стране он живет: в странах с высоким уровнем дохода от рака излечиваются более 80% заболевших детей, в то время ...
Кишечная палочка (бактерия Escherichia coli (E. coli)), часто обнаруживается в кишечнике людей и теплокровных животных. Большинство штаммов E. coli безвредны. Однако некоторые штаммы, могут вызывать тяжелые болезни. ...
Хроническая обструктивная болезнь легких (ХОБЛ) – третья причина смерти по всем мире, от которой в 2019 г. умерло 3,23 млн человек. ...
Пневмококковая инфекция может вызывать такие тяжелые инвазивные заболевания, как менингит, септицемия и пневмония, а также менее тяжелые, но более распространенные, как синусит и средний отит. ...
Ботулизм является тяжелой, потенциально смертельной, но относительно редкой болезнью. ...
В этой статье мы предлагаем несколько простых советов, которые позволят вам получить удовольствие от новогодних каникул, не оказывая значительного влияния на ваше здоровье. ...
Побаловать себя праздничным застольем, но при этом сохранить фигуру? Оказывается, это возможно, если правильно организовать свое меню! ...